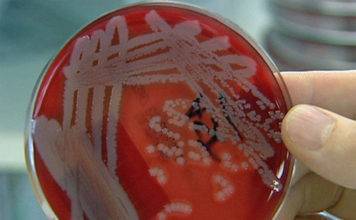
CPS crea conciencia sobre la leptospirosis

POPULAR VIDEOS
- All
- Blog
- Business News
- Devotion
- Dutch News
- English News
- Entertainment
- Explicit Content
- Featured
- Featured Videos
- Food & Beverages
- French News
- Headlines & Top Stories
- Health
- Health & Fitness
- Lifestyle
- Local News
- Papiamentu News
- Photography
- Politics
- Region & Caribbean
- Reviews
- Spanish News
- Sports News
- Travel
- Videos
- Weather
- World News
More
MOVIE TRAILERS
Advertisement [huge_it_slider id="3"]
GAMEPLAY
TRENDING NOW
TOP REVIEWS
DON'T MISS
- All
- Blog
- Business News
- Devotion
- Dutch News
- English News
- Entertainment
- Explicit Content
- Featured
- Featured Videos
- Food & Beverages
- French News
- Headlines & Top Stories
- Health
- Health & Fitness
- Lifestyle
- Local News
- Papiamentu News
- Photography
- Politics
- Region & Caribbean
- Reviews
- Spanish News
- Sports News
- Travel
- Videos
- Weather
- World News
More
LATEST ARTICLES
OPINION: When Concern Is an Act of Love
Dear Editor,
Over the past few days I have read the reflections circulating online from St. Martiners, especially young St. Martiners, with a mixture of...
BHRO President Addresses CSW70 on Peace, Justice, and Women’s Leadership
Bonaire’s Voice Reaches the United Nations: The President of the Bonaire Human Rights Organization, Davika Bissessar Shaw, delivered an impactful and eloquent address during a...
The Department of Food Safety of the Inspectorate Emphasizes Food Safety through CTP project.
PHILIPSBURG, Sint Maarten -- The Food Safety division of the Inspectorate VSA is responsible for assuring that foods prepared and sold in Sint Maarten...
Minister Arrindell attends UN 70th Commission of the Status of Women Session
THE NETHERLANDS (THE HAGUE) – Her Excellency the Minister Plenipotentiary Drs. Gracita Arrindell recently attended the opening of the 70th session of the United...
Police Investigating Shooting Incident in Island Harbour
The Valley, Anguilla -- The Royal Anguilla Police Force (RAPF) is investigating a report of a shooting incident which occurred on Friday, March 13,...
Urgent Call for National Preparedness: Sint Maarten MPs Request Parliamentary Meeting on Future of...
PHILIPSBURG, Sint Maarten – The Democratic Party (DP) faction, together with several other Members of Parliament, has formally requested that the Chair of Parliament...
Government Website Offline
GREAT BAY, Sint Maarten (DCOMM) – The Department of Communication (DCOMM) hereby informs the general public that the official Government of Sint Maarten website, www.sintmaartengov.org,...
2026 SMVTS Career Fair
The St. Maarten Vocational Training School (SMVTS) successfully hosted its annual Career Fair, providing students with meaningful exposure to career pathways, vocational skills, and ...
MP Roseburg Visits Aruba’s SVT Program, Explores Use of Crime Fund to Support Youth...
PHILIPSBURG / ARUBA — Member of Parliament Sjamira D. M. Roseburg, who was invited to Aruba last week Thursday in her capacity as a...
Digitisation Equipment Purchased For Museum
The Sint Maarten National Heritage Foundation & Museum has received funding from the Mondriaan Fund to support the digitisation of its historical collections.
With this...